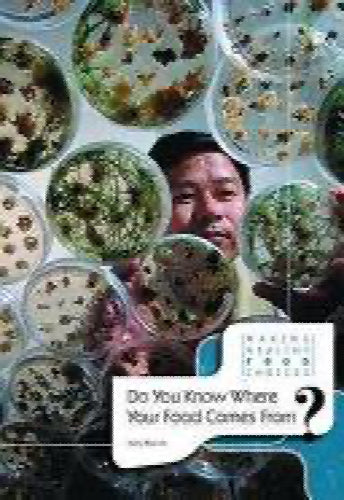

Do You Know where Your Food Comes From? by Neil Morris
Why do we worry so much about what we eat? Does it really metter where it comes from? Why is the information so confusing? The foods we choose affect people's jobs, animal welfare, and the environment. So it does matter where it comes from. This book explains how the global food business and the demands of supermarkets affect agriculture, our eating habits, and our health.
Publication Details
Title:
Author(s):
Illustrator:
Binding: Hardcover
Published by: Heinemann Library: , 2006
Edition:
ISBN: 9780431119175 | 0431119171
56 pages.
Book Condition: Good
Ex-library
Pickup available at Book Express Warehouse
Usually ready in 4 hours
Product information


New Zealand Delivery
Shipping Options
Shipping options are shown at checkout and will vary depending on the delivery address and weight of the books.
We endeavour to ship the following day after your order is made and to have pick up orders available the same day. We ship Monday-Friday. Any orders made on a Friday afternoon will be sent the following Monday. We are unable to deliver on Saturday and Sunday.
Pick Up is Available in NZ:
Warehouse Pick Up Hours
- Monday - Friday: 9am-5pm
- 35 Nathan Terrace, Shannon NZ
Please make sure we have confirmed your order is ready for pickup and bring your confirmation email with you.
Rates
-
New Zealand Standard Shipping - $6.00
- New Zealand Standard Rural Shipping - $10.00
- Free Nationwide Standard Shipping on all Orders $75+
Please allow up to 5 working days for your order to arrive within New Zealand before contacting us about a late delivery. We use NZ Post and the tracking details will be emailed to you as soon as they become available. There may be some courier delays that are out of our control.
International Delivery
We currently ship to Australia and a range of international locations including: Belgium, Canada, China, Switzerland, Czechia, Germany, Denmark, Spain, Finland, France, United Kingdom, United States, Hong Kong SAR, Thailand, Philippines, Ireland, Israel, Italy, Japan, South Korea, Malaysia, Netherlands, Norway, Poland, Portugal, Sweden & Singapore. If your country is not listed, we may not be able to ship to you, or may only offer a quoting shipping option, please contact us if you are unsure.
International orders normally arrive within 2-4 weeks of shipping. Please note that these orders need to pass through the customs office in your country before it will be released for final delivery, which can occasionally cause additional delays. Once an order leaves our warehouse, carrier shipping delays may occur due to factors outside our control. We, unfortunately, can’t control how quickly an order arrives once it has left our warehouse. Contacting the carrier is the best way to get more insight into your package’s location and estimated delivery date.
- Global Standard 1 Book Rate: $37 + $10 for every extra book up to 20kg
- Australia Standard 1 Book Rate: $14 + $4 for every extra book
Any parcels with a combined weight of over 20kg will not process automatically on the website and you will need to contact us for a quote.
Payment Options
On checkout you can either opt to pay by credit card (Visa, Mastercard or American Express), Google Pay, Apple Pay, Shop Pay & Union Pay. Paypal, Afterpay and Bank Deposit.
Transactions are processed immediately and in most cases your order will be shipped the next working day. We do not deliver weekends sorry.
If you do need to contact us about an order please do so here.
You can also check your order by logging in.
Contact Details
- Trade Name: Book Express Ltd
- Phone Number: (+64) 22 852 6879
- Email: sales@bookexpress.co.nz
- Address: 35 Nathan Terrace, Shannon, 4821, New Zealand.
- GST Number: 103320957 - We are registered for GST in New Zealand
- NZBN: 9429031911290
We have a 30-day return policy, which means you have 30 days after receiving your item to request a return.
To be eligible for a return, your item must be in the same condition that you received it, unworn or unread.
To start a return, you can contact us at sales@bookexpress.co.nz. Please note that returns will need to be sent to the following address: 35 Nathan Terrace, Shannon, New Zealand 4821.
If your return is for a quality or incorrect item, the cost of return will be on us, and will refund your cost. If it is for a change of mind, the return will be at your cost.
You can always contact us for any return question at sales@bookexpress.co.nz.
Damages and issues
Please inspect your order upon reception and contact us immediately if the item is defective, damaged or if you receive the wrong item, so that we can evaluate the issue and make it right.
Exceptions / non-returnable items
Certain types of items cannot be returned, like perishable goods (such as food, flowers, or plants), custom products (such as special orders or personalised items), and personal care goods (such as beauty products). Although we don't currently sell anything like this. Please get in touch if you have questions or concerns about your specific item.
Unfortunately, we cannot accept returns on gift cards.
Exchanges
The fastest way to ensure you get what you want is to return the item you have, and once the return is accepted, make a separate purchase for the new item.
European Union 14 day cooling off period
Notwithstanding the above, if the merchandise is being shipped into the European Union, you have the right to cancel or return your order within 14 days, for any reason and without a justification. As above, your item must be in the same condition that you received it, unworn or unused, with tags, and in its original packaging. You’ll also need the receipt or proof of purchase.
Refunds
We will notify you once we’ve received and inspected your return, and let you know if the refund was approved or not. If approved, you’ll be automatically refunded on your original payment method within 10 business days. Please remember it can take some time for your bank or credit card company to process and post the refund too.
If more than 15 business days have passed since we’ve approved your return, please contact us at sales@bookexpress.co.nz.